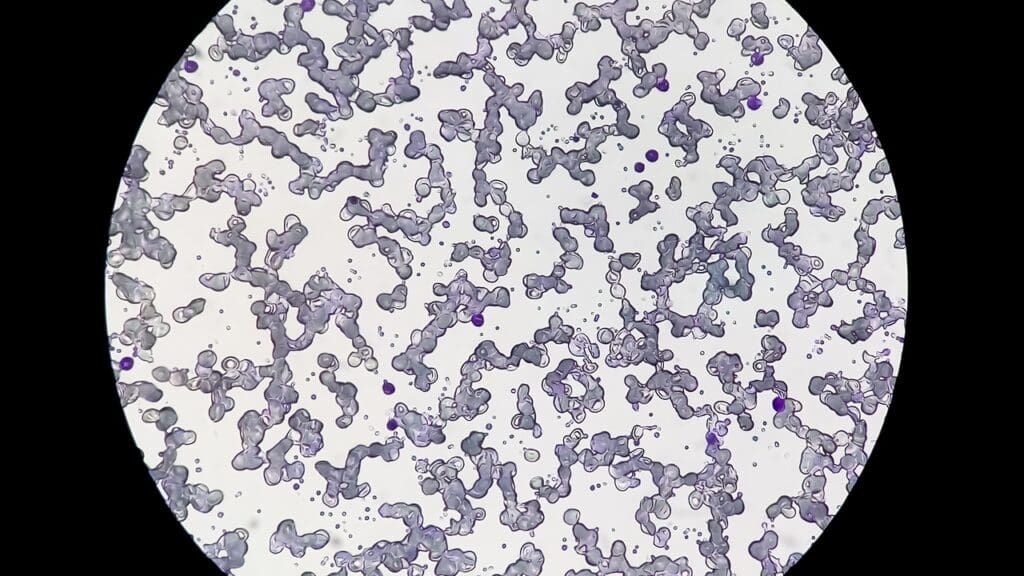
dlbcl stage 4 dlbcl stage 4

It’s vital to understand diffuse large B-cell lymphoma stage 4 for those seeking care. At Liv Hospital, we offer top-notch healthcare and support for international patients.
Diffuse large B-cell lymphoma (DLBCL) is a serious form of non-Hodgkin lymphoma. It spreads to organs like the liver or bone marrow. This calls for detailed care and advanced treatments.
We’ll share key facts about DLBCL stage 4. This includes symptoms, staging, and treatment options. Our goal is to help patients make informed choices about their care.
Key Takeaways
- DLBCL stage 4 is an advanced form of non-Hodgkin lymphoma.
- The cancer has spread to at least one organ outside the lymphatic system.
- Symptoms and staging are critical in determining the treatment plan.
- Advanced treatment options are available for patients with DLBCL stage 4.
- Comprehensive care is essential for international patients seeking treatment.
Understanding DLBCL: What Is Diffuse Large B-Cell Lymphoma?
DLBCL, or Diffuse Large B-Cell Lymphoma, is the most common type of non-Hodgkin lymphoma. It grows quickly and has unique features. We will explore its definition and classification.
Definition and Classification of DLBCL
DLBCL is a fast-growing non-Hodgkin lymphoma. It starts from B cells, which are important for our immune system. The World Health Organization (WHO) classifies DLBCL into subtypes based on its appearance, genetics, and how it behaves.
How DLBCL Differs from Other Lymphomas
DLBCL stands out because of its large cells and how they grow. It’s aggressive and needs quick treatment. Doctors diagnose it through a biopsy, looking for the big B cells.
Risk Factors and Incidence Rates
Several factors increase the risk of getting DLBCL. These include being over 60, having weakened immunity, or being exposed to harmful chemicals. The disease is more common in developed countries.
| Age Group | Male Incidence Rate | Female Incidence Rate |
|---|---|---|
| 0-19 | 0.3 | 0.2 |
| 20-39 | 1.2 | 0.9 |
| 40-59 | 3.5 | 2.5 |
| 60+ | 7.8 | 5.6 |
Knowing about DLBCL is key for doctors and patients. By understanding its risk factors, symptoms, and characteristics, we can aim for early diagnosis and effective treatments.
The Lymphoma Staging System Explained
For those with DLBCL, understanding lymphoma staging is key. We’ll cover the staging system, focusing on the Ann Arbor classification.
Ann Arbor Staging Classification
The Ann Arbor system is key for staging lymphomas, like DLBCL. It looks at lymph node involvement and symptoms. This helps decide the treatment plan.
The Ann Arbor staging is as follows:
- Stage I: A single lymph node group or structure is involved.
- Stage II: Two or more lymph node groups on one side of the diaphragm are involved.
- Stage III: Lymph node groups on both sides of the diaphragm are involved.
- Stage IV: The disease spreads to organs like the liver, bone marrow, or lungs.
The Role of B Symptoms in Staging
B symptoms, like fever and weight loss, are important in staging. They show if the disease is more advanced. This affects how it’s treated.
Patients with B symptoms are marked with “B.” For example, Stage III DLBCL with B symptoms is Stage IIIB.
Diagnostic Tools Used for Staging
Several tools help stage DLBCL:
- Imaging Studies: PET/CT scans and MRI check lymph node involvement and extranodal disease.
- Biopsy and Pathology: Biopsy samples confirm the diagnosis and assess the lymphoma’s features.
- Blood Tests: Blood tests, like complete blood counts and LDH levels, give insights into the patient’s health and disease burden.
Accurate staging is vital for predicting outcomes and planning treatment for DLBCL patients.
DLBCL Stage 4: What It Means for Patients
Getting a stage 4 DLBCL diagnosis can feel overwhelming. But knowing what it means is key to moving forward. We’re here to offer detailed info and support to help you through this tough time.
Definition and Characteristics of Stage 4 DLBCL
Stage 4 DLBCL means the cancer has spread to organs outside the lymph nodes. This includes places like the liver, bone marrow, or lungs. It shows the cancer has moved beyond the lymph nodes to other parts of the body.
The key traits of stage 4 DLBCL are:
- Widespread disease: The cancer is in many organs or tissues.
- Extranodal involvement: Organs outside the lymph system are affected.
- Advanced cancer stage: It needs urgent and thorough treatment.
Organs Commonly Affected in Stage 4
Several organs are often hit by stage 4 DLBCL. These include:
- Liver: The liver is a common spot for cancer to spread.
- Bone marrow: Bone marrow involvement can cause many problems.
- Lungs: Lymphoma in the lungs can lead to breathing issues.
- Bones: Cancer in bones can cause pain and increase fracture risk.
- Central nervous system: In some cases, the brain or spinal cord can be affected.
Extranodal Involvement Patterns
Extranodal involvement means the cancer has spread to areas outside the lymph nodes. In stage 4 DLBCL, this can happen in different ways. These include:
- Single extranodal site: The cancer might be in just one organ or tissue.
- Multiple extranodal sites: Often, stage 4 DLBCL affects many organs.
Knowing these patterns is vital for creating a good treatment plan. We’ll work with you to find the best approach based on where the cancer is.
Recognizing Stage 4 Diffuse Large B-Cell Lymphoma Symptoms
It’s important to know the symptoms of stage 4 DLBCL early. This helps in getting the right treatment quickly. At this stage, the lymphoma has spread to many parts of the body. It can affect different organs and systems.
Systemic Symptoms (B Symptoms)
B symptoms are common in lymphoma patients, including those with stage 4 DLBCL. These symptoms include:
- Fever: A body temperature over 38°C (100.4°F) that keeps coming back.
- Night Sweats: Sweating a lot at night, enough to soak through clothes and bedding.
- Weight Loss: Losing weight without trying, often a lot in a short time.
B symptoms show how the body is fighting the lymphoma. They can really affect a patient’s life quality.
Organ-Specific Symptoms Based on Involvement
Patients with stage 4 DLBCL may also have symptoms based on where the lymphoma is. For example:
| Organ/System Affected | Possible Symptoms |
|---|---|
| Liver | Abdominal swelling, jaundice, feeling very tired |
| Bone Marrow | Feeling very tired, anemia, getting sick more easily |
| Gastrointestinal Tract | Stomach pain, feeling sick, vomiting, changes in bowel movements |
These symptoms can be different for each patient. It depends on where the lymphoma is.
Distinguishing Symptoms from Other Conditions
It’s key to tell the symptoms of stage 4 DLBCL from other diseases. Some symptoms can be similar. A detailed check-up, including tests and biopsies, is needed to confirm lymphoma. This helps in choosing the right treatment.
Knowing the symptoms of stage 4 DLBCL helps patients and doctors manage the disease better. This improves the patient’s quality of life.
Comparing DLBCL Stages: From Stage 2 to Stage 4
The stages of DLBCL, from Stage 2 to Stage 4, show how far the lymphoma has spread. Knowing these stages helps doctors choose the right treatment and guess how well it will work.
Stage 2 B Cell Lymphoma: Limited Regional Spread
Stage 2 DLBCL means the lymphoma is in two or more lymph node groups on one side of the diaphragm. This shows the disease is mostly in one area. At this stage, treatment usually includes chemotherapy and/or radiation to stop it from spreading more.
Stage 3 Large B Cell Lymphoma: Involvement on Both Sides of Diaphragm
Stage 3 DLBCL has spread to lymph nodes on both sides of the diaphragm. This means the disease is more widespread. Chemotherapy is often used to fight the spread of the cancer.
Stage 4 DLBCL: Disseminated Disease and Organ Involvement
Stage 4 DLBCL is the most serious, with lymphoma in organs like the liver, bone marrow, or lungs. This stage needs very aggressive treatment, like chemotherapy, immunotherapy, and sometimes stem cell transplants. The goal is to get the disease under control and improve survival chances.
Looking at these stages shows how DLBCL gets worse and how treatment needs to change. As the disease gets more advanced, treatment gets more complex. The focus shifts from just treating the area to managing the disease throughout the body.
Diagnostic Process for Advanced DLBCL
Diagnosing advanced DLBCL involves several steps. These include a physical check-up, advanced imaging, and detailed pathology tests. This process might seem complex, but it’s key to finding the right treatment.
Initial Assessment and Physical Examination
The first step is an initial assessment. Healthcare providers collect medical history and perform a detailed physical exam. This helps spot symptoms or signs of DLBCL, like swollen lymph nodes.
Our team looks for:
- Enlarged lymph nodes or tumors
- Splenomegaly (enlarged spleen)
- Hepatomegaly (enlarged liver)
- Other signs of organ involvement
Imaging Studies: PET/CT, MRI, and Ultrasound
Imaging studies are vital for diagnosing and staging DLBCL. We use different imaging methods to see how far the disease has spread.
The most common imaging studies include:
- PET/CT (Positron Emission Tomography/Computed Tomography) scans, which provide detailed information about metabolic activity and anatomical structures.
- MRI (Magnetic Resonance Imaging), which offers high-resolution images of soft tissues and organs.
- Ultrasound, which can help evaluate lymph nodes and organs, specially in the abdominal region.
Biopsy and Pathology Testing
A biopsy is the main way to diagnose DLBCL. We take tissue samples through biopsy procedures. These samples are then checked by pathologists to confirm cancer and the type of lymphoma.
The biopsy process involves:
- Obtaining a tissue sample from an affected lymph node or organ
- Preparing the sample for histopathological examination
- Analyzing the tissue for characteristic features of DLBCL, such as large B cells and specific markers
As a leading expert notes, “Accurate diagnosis through biopsy and pathology testing is vital for effective treatment planning for DLBCL patients.” We make sure our patients get thorough and precise diagnostic evaluations to guide their care.
Standard Treatment Approaches for Stage 4 DLBCL
Managing stage 4 diffuse large B-cell lymphoma (DLBCL) involves a detailed treatment plan. We will look at the main treatment methods. These include the most used protocols and how they are given.
R-CHOP Immunochemotherapy Protocol
The R-CHOP protocol is a key treatment for DLBCL. It combines rituximab, a monoclonal antibody, with chemotherapy agents like cyclophosphamide, doxorubicin, vincristine, and prednisone.
Rituximab has greatly improved DLBCL treatment results. The R-CHOP protocol is given in cycles, every 21 days. This allows for bone marrow and tissue recovery.
Treatment Cycles, Duration, and Administration
R-CHOP treatment usually lasts for 6 cycles, each 21 days long. The exact schedule may change based on patient response and tolerance.
| Treatment Cycle | Day 1 | Days 1-5 |
|---|---|---|
| R-CHOP | Rituximab, Cyclophosphamide, Doxorubicin, Vincristine | Prednisone |
Supportive care, like antiemetics and growth factors, helps manage side effects and prevent complications.
Response Assessment During Treatment
After 3-4 cycles of R-CHOP, treatment response is checked again after all planned treatment is done. PET/CT scans are used for this.
We judge response by tumor size reduction, symptom resolution, and overall improvement. Treatment plans may be adjusted based on these assessments.
Advanced and Emerging Therapies for Refractory Cases
Managing refractory DLBCL has seen new therapies. These options offer hope for better outcomes for those who don’t respond to initial treatments.
Second-Line Treatment Options
When DLBCL doesn’t respond to first-line treatment, second-line options are considered. These include different chemotherapy regimens and targeted therapies. R-DHAP and R-ICE are common second-line treatments.
The right second-line treatment depends on the patient’s health, past treatments, and disease characteristics.
| Treatment Regimen | Components | Typical Use |
|---|---|---|
| R-DHAP | Rituximab, Dexamethasone, Cytarabine, Cisplatin | Second-line treatment for refractory DLBCL |
| R-ICE | Rituximab, Ifosfamide, Carboplatin, Etoposide | Second-line treatment, before stem cell transplantation |
Stem Cell Transplantation Procedures
Stem cell transplantation is a curative option for some patients. There are two types: autologous and allogeneic.
Autologous stem cell transplantation is often used for DLBCL. It involves high-dose chemotherapy followed by reinfusion of the patient’s stem cells.
CAR T-Cell Therapy and Immunotherapy Advances
CAR T-cell therapy is a big step forward in treating refractory DLBCL. It modifies T-cells to attack cancer cells.
Key benefits of CAR T-cell therapy include:
- Potential for durable responses in heavily pretreated patients
- Ability to target cancer cells directly
- Ongoing research to improve and reduce side effects
Other immunotherapy advances, like checkpoint inhibitors and bispecific antibodies, are also being explored for refractory DLBCL.
Prognosis and Survival Rates for Stage 4 DLBCL
Knowing the prognosis for Stage 4 Diffuse Large B-Cell Lymphoma (DLBCL) is key for patients. It helps them understand their treatment journey better. Prognosis is about the likely outcome of a disease. For Stage 4 DLBCL, it includes many factors that affect survival and treatment success.
Understanding 5-Year Survival Statistics
The 5-year survival rate is a key measure for cancer patients, including those with DLBCL. It shows the percentage of patients alive 5 years after diagnosis. Thanks to new treatments, survival rates for DLBCL have gone up. This gives patients a more hopeful outlook.
Key factors contributing to improved survival rates include:
- Advancements in immunochemotherapy protocols
- Increased accessibility to targeted therapies
- Improved supportive care measures
Prognostic Factors That Influence Outcomes
Several factors are important in predicting outcomes for Stage 4 DLBCL patients. These factors help doctors guess how the disease will progress and how well a patient will respond to treatment.
Important prognostic factors include:
- Age of the patient at diagnosis
- Performance status, reflecting the patient’s overall health and ability to carry out daily activities
- Presence of B symptoms (fever, night sweats, weight loss)
- Stage and extent of disease spread
- Lactate dehydrogenase (LDH) levels, which can indicate tumor burden
International Prognostic Index (IPI) Score
The International Prognostic Index (IPI) is a tool used to predict outcomes for non-Hodgkin lymphoma, including DLBCL. It considers age, performance status, LDH levels, stage, and extranodal sites involved.
The IPI score groups patients by risk, from low to high. This helps tailor treatments to each patient’s prognosis.
Understanding these factors and the IPI score helps healthcare providers give more personalized care. This improves outcomes for Stage 4 DLBCL patients.
Living with Stage 4 DLBCL: Coping Strategies
Dealing with Stage 4 DLBCL is more than just treatment. It’s about taking care of your whole self. This means managing symptoms and keeping your emotional health strong.
Managing Physical Symptoms During Treatment
It’s key to manage physical symptoms to keep your quality of life up. Effective symptom management can make you feel better and help your treatment work better. Symptoms like fatigue, pain, and nausea are common.
- Fatigue can be managed by pacing activities and incorporating rest periods.
- Pain management may involve medication, alternative therapies like acupuncture, or relaxation techniques.
- Nausea can be alleviated with anti-nausea medication, dietary changes, and avoiding strong odors.
Emotional and Psychological Support Resources
Getting emotional and psychological support is critical when facing a DLBCL diagnosis. Support groups, whether in-person or online, offer a sense of community. Professional counseling or therapy can help with anxiety and depression.
Also, resources like:
- Patient advocacy organizations
- Mental health professionals specializing in cancer care
- Online forums and support groups
can provide valuable guidance and emotional support.
Nutrition and Exercise Considerations
Nutrition and exercise are important for managing Stage 4 DLBCL. A balanced diet helps keep you strong and supports recovery during treatment.
Nutritional tips include:
- Eating small, frequent meals to manage nausea and maintain nutrition.
- Staying hydrated by drinking plenty of fluids.
- Avoiding foods that are difficult to digest or cause discomfort.
Starting with gentle exercises like walking or yoga can help. Always talk to your healthcare provider before starting any new exercise.
Follow-up Care and Monitoring After Treatment
After treatment, DLBCL patients enter a critical phase. This phase is key for catching any signs of recurrence. It also helps manage long-term side effects and ensures overall health.
Follow-up care includes regular check-ups and imaging tests. These help monitor your health. We’ll cover the typical surveillance schedule, signs of recurrence, and long-term health considerations. This will help you navigate this phase effectively.
Surveillance Schedule and Testing Protocols
A structured follow-up schedule is vital for monitoring patients after DLBCL treatment. The frequency of visits and tests varies based on individual factors, treatment response, and doctor’s advice.
| Time Post-Treatment | Follow-up Actions |
|---|---|
| 0-3 months | Monthly check-ups, imaging tests (e.g., PET/CT scans) |
| 3-6 months | Bi-monthly check-ups, continued imaging as needed |
| 6-12 months | Quarterly check-ups, reduced frequency of imaging |
| 1-2 years | Semi-annual check-ups, monitoring for late effects |
Regular follow-up care allows for early detection of issues and timely intervention.
Signs of Recurrence to Watch For
It’s important for patients to know the signs of DLBCL recurrence. These include:
- New or enlarging lymph nodes
- Unexplained fever, night sweats, or weight loss
- Fatigue or general feeling of being unwell
- Pain or discomfort in specific areas
If you notice any of these symptoms, contact your healthcare provider right away.
Long-term Health Considerations and Late Effects
DLBCL survivors may face late effects from treatment. These can include:
- Cardiovascular issues
- Secondary cancers
- Hormonal imbalances
- Cognitive changes
Regular follow-up care helps manage these late effects and improves quality of life.
Understanding the importance of follow-up care and being proactive about your health is key. This way, you can navigate the post-treatment phase with confidence.
Conclusion: Navigating the DLBCL Journey
Navigating DLBCL needs a full care plan, from start to finish. Knowing about DLBCL stage 4 is key for patients and their families. This includes its symptoms, how it’s staged, and treatment choices.
We’ve looked at the main facts about DLBCL stage 4. It’s vital to get a quick diagnosis and effective treatment. Spotting symptoms and knowing the staging system helps patients on their journey.
During treatment, having a strong support network is critical. This includes doctors, family, and friends. We stress the importance of full care throughout the DLBCL journey. This ensures patients get the help and support they need to manage their condition well.
With top-notch healthcare and full support, we aim to help patients face their DLBCL journey confidently. Our goal is to give patients the knowledge and tools to beat the challenges of DLBCL stage 4.
FAQ
What is DLBCL stage 4, and how is it different from other stages?
DLBCL stage 4 is an advanced stage of diffuse large B-cell lymphoma. It means the disease has spread to many lymph nodes or organs outside the lymphatic system. This stage is different because it affects many areas and is not just in the lymph nodes.
What are the common symptoms of stage 4 DLBCL?
Symptoms of stage 4 DLBCL include fever, night sweats, and weight loss. They also depend on the affected areas, like abdominal pain or neurological issues.
How is DLBCL staged, and what is the Ann Arbor staging classification?
DLBCL is staged using the Ann Arbor classification. It looks at the number of lymph nodes involved, symptoms, and if the disease has spread to other areas or across the diaphragm.
What is the R-CHOP protocol, and how is it used in treating stage 4 DLBCL?
R-CHOP is a treatment for DLBCL. It combines rituximab with cyclophosphamide, doxorubicin, vincristine, and prednisone. This treatment targets cancer cells and reduces tumor size.
What are the prognostic factors that influence outcomes in stage 4 DLBCL?
Factors that affect outcomes in stage 4 DLBCL include age, performance status, and LDH levels. Extranodal involvement and the International Prognostic Index (IPI) score also play a role.
What is the International Prognostic Index (IPI) score, and how is it used?
The IPI score helps predict how well a patient will do with DLBCL. It looks at age, stage, LDH levels, performance status, and extranodal involvement.
Are there any emerging therapies for refractory DLBCL?
Yes, new treatments for refractory DLBCL include CAR T-cell therapy. It genetically modifies T cells to attack cancer. Other immunotherapies also aim to boost the immune system’s fight against cancer.
What is the significance of 5-year survival statistics for stage 4 DLBCL?
5-year survival statistics show how many patients live 5 years after diagnosis. They help understand treatment effectiveness and the prognosis for stage 4 DLBCL.
How is follow-up care managed after treatment for DLBCL?
After DLBCL treatment, follow-up care includes regular checks with imaging and clinical assessments. This is to watch for recurrence, manage late effects, and address ongoing health issues.
What are the signs of recurrence to watch for after DLBCL treatment?
Signs of recurrence include new or growing lymphadenopathy, fever, weight loss, or symptoms related to previously involved organs.
How can patients cope with stage 4 DLBCL during treatment?
Coping with stage 4 DLBCL involves managing symptoms, getting emotional and psychological support, staying nourished, and exercising. Healthcare teams provide resources to help.
What are the considerations for nutrition and exercise during DLBCL treatment?
Nutrition is key during DLBCL treatment to manage side effects and keep strength up. Exercise can improve function and well-being, but it must be tailored to the patient’s condition and treatment phase